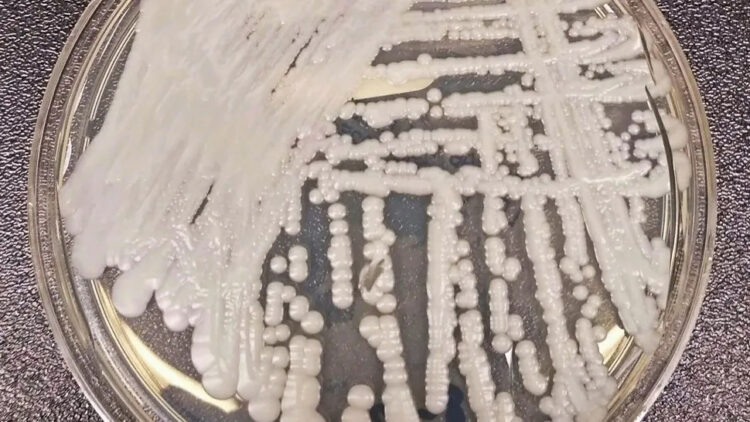
Detectan dos casos de un superhongo en CABA: qué es y qué síntomas tiene

La jornada fue impulsada por la Federación Internacional de Diabetes (FID) y la Organización Mundial de la Salud (OMS) para concientizar sobre sus riesgos y métodos de prevención

El 14 de noviembre se conmemora el Día Mundial de la Diabetes: una iniciativa impulsada por la Federación Internacional de Diabetes (FID) y la Organización Mundial de la Salud (OMS) que busca concientizar a la sociedad sobre los riesgos de esta enfermedad.
Fue en 1991, cuando se decidió elegir un día para la lucha contra la diabetes, honrando el nacimiento del médico Frederick Banting, quien descubrió la insulina en 1921 junto a su colega Charles Best.
Según la Organización Mundial de la Salud, hay 450 millones de personas en el mundo con esta enfermedad. Además, en 2021, en Estados Unidos murieron más de 100.000 de personas por complicaciones relacionadas con la diabetes.
¿Qué es la diabetes?
Esta enfermedad es un trastorno metabólico que se produce en el páncreas, cuando este órgano no es capaz de elaborar la cantidad necesaria de insulina o no es producido cuando el páncreas no fabrica suficiente insulina o el organismo no la gestiona adecuadamente. El problema es que esta hormona se encarga de nivelar la azúcar en sangre, por lo que si no logra hacerlo se puede producir una hiperglucemia.

En principio, esta enfermedad no suele manifestar una sintomatología evidente. Es por ello que se recomienda realizar exámenes de sangre y chequeos médicos con frecuencia, teniendo en cuenta los antecedentes familiares del paciente.
Algunos de los síntomas de la diabetes son:
- Cansancio y fatiga
- Pérdida de peso
- Visión borrosa
- Llagas de curación lenta
- Infecciones cutáneas
- Sensación de hormigueo en manos y pies
- Sed excesiva y orina frecuente
Tipos de diabetes
- Tipo 1: se produce por factores internos del cuerpo humano cuando no logra producir la insulina necesaria.
- Tipo 2: se da cuando la insulina no es administrada de manera correcta, en muchos casos a causa de un índice de masa corporal e índice de grasa corporal elevados.
- Gestacional: aparece durante el embarazo, por el aumento de azúcar en sangre durante estos meses.
¿Cómo prevenir la diabetes?
Es importante aclarar que la diabetes del tipo 1 no puede prevenirse, ya que se da por un proceso biológico del cuerpo humano. Sin embargo, si existen antecedentes familiares, es recomendable acudir al médico con frecuencia para revisar los valores pertinentes.
Para reducir los otros tipos de diabetes o bien prevenir su aparición, se recomienda llevar una vida saludable con los siguientes hábitos:
- Dieta baja en carbohidratos y una alimentación sana puede ayudar a mantener los niveles de azúcar en sangre
- Realizar ejercicio regularmente, al menos por media hora, durante 5 días a la semana
- No fumar
- Consumir alimentos ricos en fibras, ya que reducen los niveles de glucosa en la sangre y retrasan la absorción del azúcar: frutas, vegetales sin almidón, legumbres y cereales integrales
- Sustituir las grasas comunes por saludables, como el aceite de oliva, frutos secos y pescados grasos como el salmón, atún y bacalao.
- Beber suficiente agua al día
- Mantener un consumo bajo de carbohidratos refinados
- Evitar el sedentarismo
- Controlar los niveles de vitamina D, ya que esta regula el nivel de azúcar en sangre
- Reducir la ingesta de alimentos procesados
Fuente: La Nacion